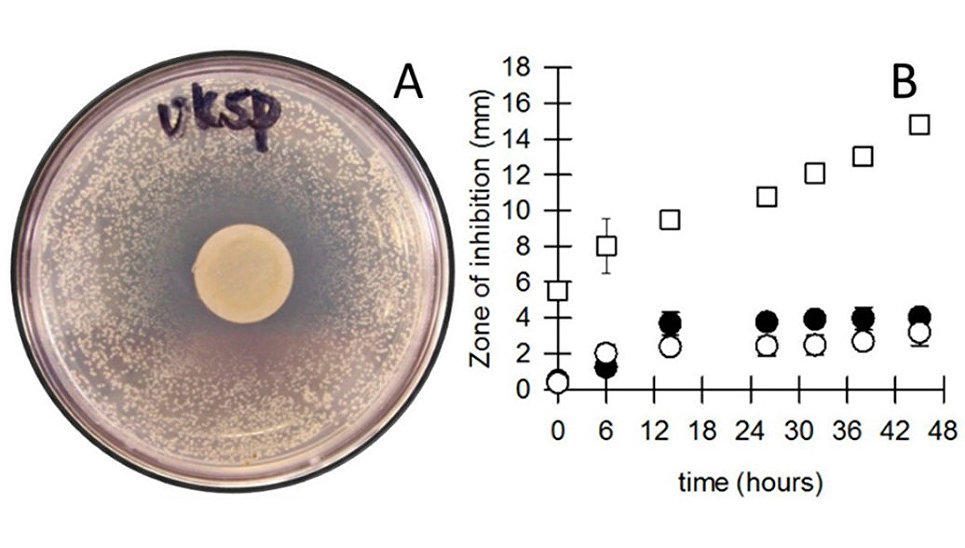

Грязные и заразные: на каких деньгах микробов больше
Банковские карточки не только удобнее, но и безопаснее бумажных денег и монет. Микробов и патогенных бактерий, обитающих на одной банкноте, вполне хватит на небольшую эпидемию. Кто живет на купюрах, можно ли от них заразиться и как отмывают грязные деньги - в материале РИА Новости, который представляет Day.Az.
Чьи купюры заразнее
Пятидесятирублевые банкноты - возможно, самые грязные деньги, которые вы когда-либо держали в руках. Исследование, проведенное десять лет назад сотрудниками "Гознака" и НИЦ эпидемиологии и микробиологии имени Н. Ф. Гамалеи, выявило на них 34 вида патогенных микроорганизмов, вызывающих туберкулез, пневмонию, менингит и много других неприятных болезней.
Американские однодолларовые купюры еще более грязные и "живые". Как установила группа ученых из Университета Нью-Йорка (США), на этих банкнотах обитает почти четыреста видов опасных микроорганизмов. Больше всего - бактерий, от которых возникают акне, угревая сыпь и другие воспаления кожи (Propionibacterium acnes, Staphylococcus epidermidis), микроорганизмов, ассоциированных с вагинальным трактом (Corynebacterium aurimucosum), микробов из полости рта (Micrococcus luteus, Streptococcus oralis) и болезнетворных вирусов.
Но самые густонаселенные - бразильские реалы: на них нашли более трех тысяч микробных родов.

Электронная микрофотография поверхностей бумажной банкноты (китайский юань), купюры, изготовленной с использованием рисовой бумаги (японская иена), американского доллара, сделанного из хлопчатобумажного волокна, и пластиковой банкноты (австралийский доллар).
Кроме бактерий на деньгах живут споры грибов и возбудители практически всех гельминтозных заболеваний (проще говоря, глисты). Иногда встречаются фрагменты ДНК домашних животных и частицы наркотиков. По данным американских токсикологов, почти на 80 процентах однодолларовых купюр есть следы кокаина, попадаются также опиаты и амфетамины.
Самые опасные
Неприятнее всего обитающие на деньгах кишечная палочка (Escherichia coli), сальмонеллы и золотистый стафилококк (Staphylococcus aureus), вызывающие соответственно тяжелые пищевые отравления, сальмонеллез, пневмонию и менингит.
Все эти бактерии Всемирная организация здравоохранения считает критически и сильно опасными для человека, так как отдельные штаммы показывают высокую резистентность к антибиотикам. Кстати, на некоторых американских и канадских банкнотах ученые уже обнаружили разновидность стафилококка MRSA, с которой не справляются даже антибиотики последнего резерва.
Храните ваши денежки
Болезнетворные микробы живут на купюрах довольно долго - от одного до двух месяцев. В бумажных деньгах много целлюлозы, а это для бактерий очень питательная среда. На пластиковых купюрах (например, австралийских долларах) и металлических монетах микроорганизмов в разы меньше, и жизнь их коротка - полторы-две недели.
Интересно, что у бактерий есть свои предпочтения в монетах. Так, кишечные палочки и сальмонеллы особенно часто встречаются на американских центах, в которых много меди. Они живут там до 11 дней.
Многие монеты подавляют рост бактерий на чашке Петри, причем степень подавления зависит и от вида бактерии, и от состава монетного сплава. На графике показано изменение границ зоны подавления с течением времени для нескольких монет. Белые квадраты - одноцентовая монета (Нидерланды, бронза), черные кружки - 20 центов (Австралия, 75% Cu, 25% Ni), белые кружки - один доллар (Австралия, 92% Cu, 6% Al, 2% Ni).
Безопаснее всего монеты с добавками серебра и золота - благородные металлы сильно ограничивают возможности роста и размножения микробов. Уже через неделю после того, как такая монета выходит из обращения, микроорганизмов на ней не остается.
Отмыть и обезвредить
Впрочем, как показали исследования американских ученых, риск заразиться инфекцией от денег невелик. Наличность больше способствует миграции микробов с континента на континент и распространению среди них генов устойчивости к антибиотикам, считают гонконгские исследователи.
В некоторых странах деньги обеззараживают озоном и ультрафиолетом. В Японии специальное устройство в банкоматах перед выдачей нагревает купюры до двухсот градусов. Этого достаточно, чтобы избавиться от бактерий, грибков и плесени.
А вот евро можно брать в руки безо всяких опасений: на них практически не бывает микробов, поскольку купюры защищены особыми антибактериальными растворами. В России самая чистая - памятная сторублевка, выпущенная к нынешнему чемпионату мира по футболу. Она сделана из полимерных материалов, препятствующих размножению патогенов.
Другие интересные новости читайте на странице Day.Az в Facebook
Заметили ошибку в тексте? Выберите текст и сообщите нам, нажав Ctrl + Enter на клавиатуре